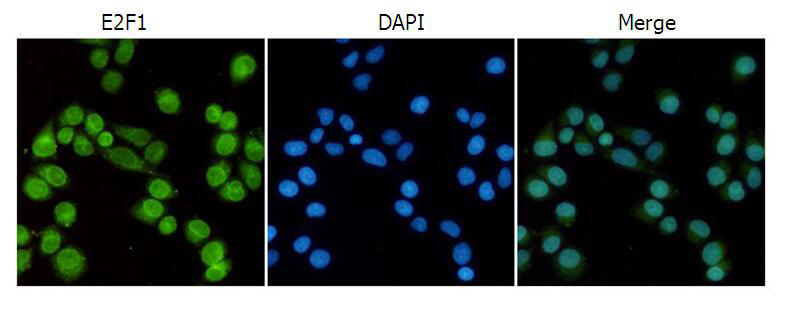

中文名稱: 小鼠抗E2F1單克隆抗體
|
Background: |
The protein encoded by this gene is a member of the E2F family of transcription factors. The E2F family plays a crucial role in the control of cell cycle and action of tumor suppressor proteins and is also a target of the transforming proteins of small DNA tumor viruses. The E2F proteins contain several evolutionally conserved domains found in most members of the family. These domains include a DNA binding domain, a dimerization domain which determines interaction with the differentiation regulated transcription factor proteins (DP), a transactivation domain enriched in acidic amino acids, and a tumor suppressor protein association domain which is embedded within the transactivation domain. This protein and another 2 members, E2F2 and E2F3, have an additional cyclin binding domain. This protein binds preferentially to retinoblastoma protein pRB in a cell-cycle dependent manner. It can mediate both cell proliferation and p53-dependent/independent apoptosis. |
|
Applications: |
WB, IF, IP |
|
Name of antibody: |
E2F1 |
|
Immunogen: |
Fusion protein of human E2F1 |
|
Full name: |
E2F transcription factor 1 |
|
Synonyms: |
RBP3; E2F-1; RBAP1; RBBP3 |
|
SwissProt: |
Q01094 |
|
WB Predicted band size: |
47 kDa |
|
WB Positive control: |
C6, Raw264.7 and Hela cell lysates |
|
WB Recommended dilution: |
500-2000 |
|
IF positive control: |
Hela cells |
|
IF Recommend dilution: |
50-100 |

購物車
購物車 幫助
幫助
 021-54845833/15800441009
021-54845833/15800441009
